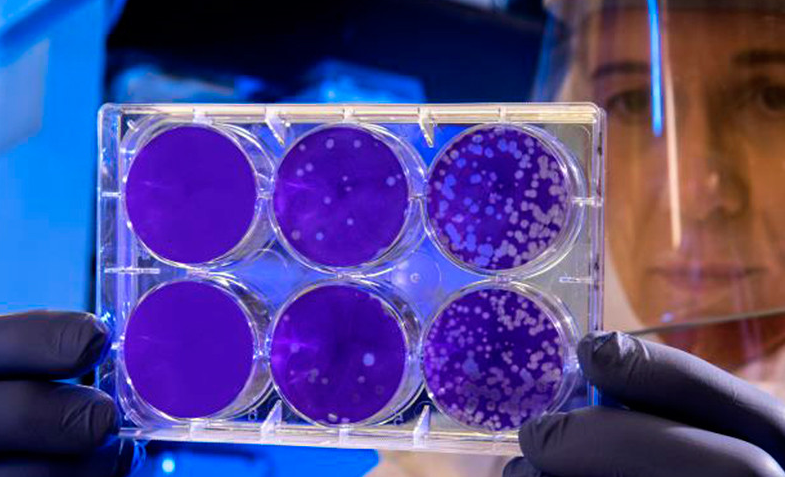

Власти Китая приняли решения с четверга запретить выезд жителей из города Хуанган, на территории которого были выявлены случаи заболевания новым опасным коронавирусом.
Как отмечается в сообщении, местным жителям запрещается покидать Хуанган, если у них нет на то особой причины. Кроме того, в городе приостанавливается работа общественного транспорта. В Хуангане также временно закрываются кинотеатры, интернет-кафе и другие развлекательные заведения. Также временно приостановлена работа центрального городского рынка.
Население Хуангана - более 6 млн человек. Он расположен недалеко от города Ухань, из которого и начал распространение вирус. Оба населенных пункта находятся в провинции Хубэй. В Ухане также с четверга приостановлено движение транспорта в другие города.
В еще одном китайском городе - Эчжоу - ранее в четверг также временно закрыли железнодорожный вокзал, но пока запрет на выезд жителей не объявили. В Эчжоу, также расположенном в провинции Хубэй, проживают около 1,1 млн человек.
Тем временем министерство здравоохранения Сингапура подтвердило первый случай заражения новым типа коронавируса, появление которого было ранее зафиксировано в Китае в городе Ухань, передает в четверг агентство Bloomberg со ссылкой на местные СМИ.
Ранее сообщалось, что в Сингапуре для проверки на вирус были госпитализированы семь человек. Кроме того, случаи заболевания уже зафиксированы в Таиланде, в Японии, Южной Корее, США, Гонконге, Тайване и Макао.
Вспышка пневмонии в китайском городе Ухань была зафиксирована в декабре 2019 года (первый случай датирован 12 декабря), возбудителем стал ранее не известный коронавирус (2019-nCoV, геном вируса уже расшифрован и опубликован).
По последним данным, 617 человек заразились вирусом, 17 человек погибли.
Всемирная организация здравоохранения (ВОЗ) 22 января провела экстренное заседание чрезвычайного комитета из-за коронавируса, но окончательного решения, является ли новый вирус глобальной угрозой, не принято; как ожидается, консультации в ВОЗ продолжатся в четверг, 23 января.
Первыми заболевшими оказались посетители местного рынка морепродуктов, позднее было установлено, что вирус передается от человека к человеку. По последним данным, заразились 217 человек, четверо умерли. Случаи заболевания зафиксированы в Южной Корее, Японии и Таиланде. Британские ученые считают, что новый коронавирус подхватили уже около 1,7 тыс. человек.
На 13:00 четверга число подтвердившихся случаев заражения новым коронавирусом в Китае составило 613, сообщил телеканал CGTN. Власти Пекина приняли решение отменить в городе все праздничные мероприятия по случаю Нового года по лунному календарю, сообщают европейские СМИ.
На такой шаг власти пошли из-за опасения дальнейшего распространения в стране коронавируса. В КНР Новый год по лунному календарю будут отмечать в ночь с 24 на 25 января.